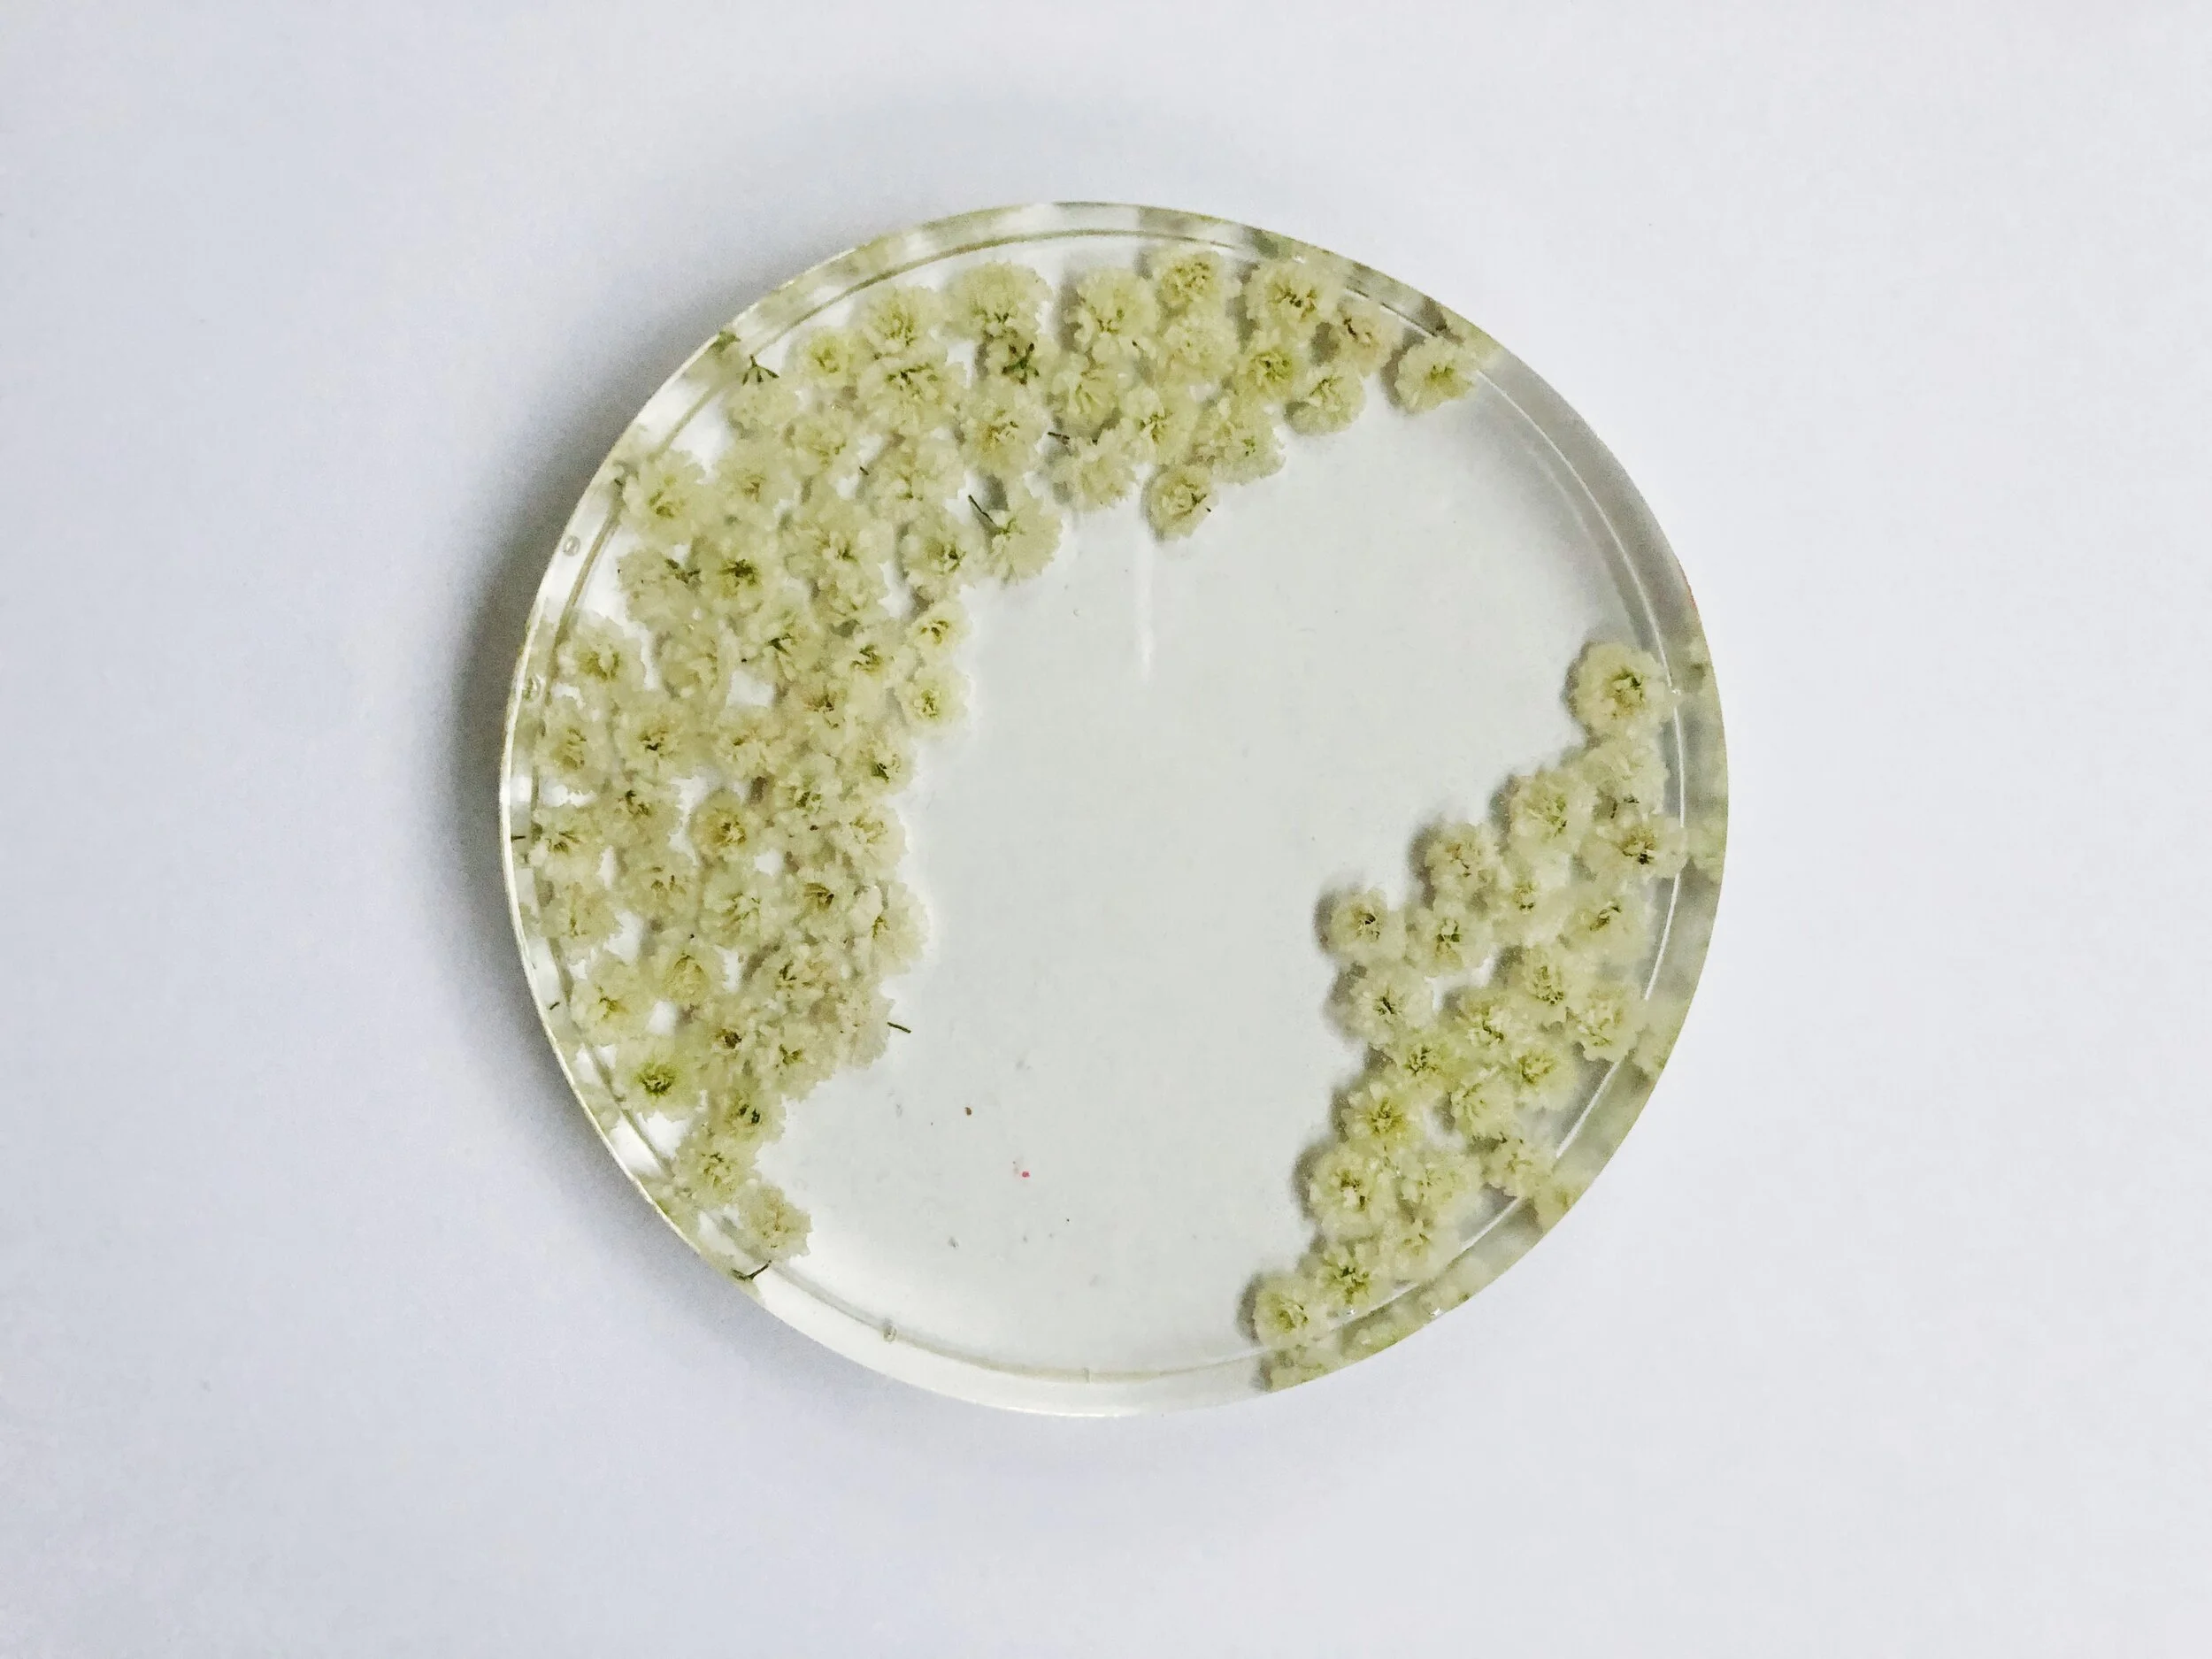
9C72DEB8-2AB7-4E8F-9F89-BE3166ABFAB1.JPG

Treasure Your Bridal Bouquet
Your wedding day can, sometimes, be a complete blur. Often times, all you have left to show for it is a ring on your hand! If you’re as sentimental as we are, you want to cherish your day every way possible. Enter: bouquet preservation by Addie’s Field.
Katie created Addie’s Field for brides who want to turn their wedding day flowers into treasured items that last a lifetime. She arrived at East Ivy Mansion at 9pm and took Jocasta’s bouquet and some centerpiece flowers and turned them into coasters for Nick and Jocasta to use in their Alaska home.
Flowers: Enchanted Florist | Venue: East Ivy Mansion | Wedding Day Photography: Emily Lester Photography
What I Do:
I take bridal bouquets and turn them into lifelong keepsakes! To have and to hold, forever!
Why I Do It:
Because it is SO SO FUN! I love working with my hands, beautiful flowers, and sentimental gifts. Craft Queen here!
How I Got Started:
I’ve always had a love for flowers. In high school, I used to pick and press wild flowers and seal them with resin into old frames from Goodwill. (That’s a little Caesars employee budget for you haha)
I started researching more ways to preserve flowers when my best friend got engaged, which led me to the methods I use now! I've been doing this for about a year, and am constantly experimenting with new pieces!
How It Works:
I take the bouquets after the wedding while the flowers are still fresh and alive. I dry them out in my workspace, which takes about 2 weeks. After the flowers are completely dried, I consult with the bride about designs/layouts. Once we decide on a final design, I begin encasing the flowers in resin. This takes another 2 weeks since I have to pour such thin layers - usually, about 12-16 layers total! It's a long process, but the end result is 100% worth the wait!
Contact:
Cell (731) 234-0050
Email: addiesfield@gmail.com
Facebook: AddiesField
Instagram: AddiesField